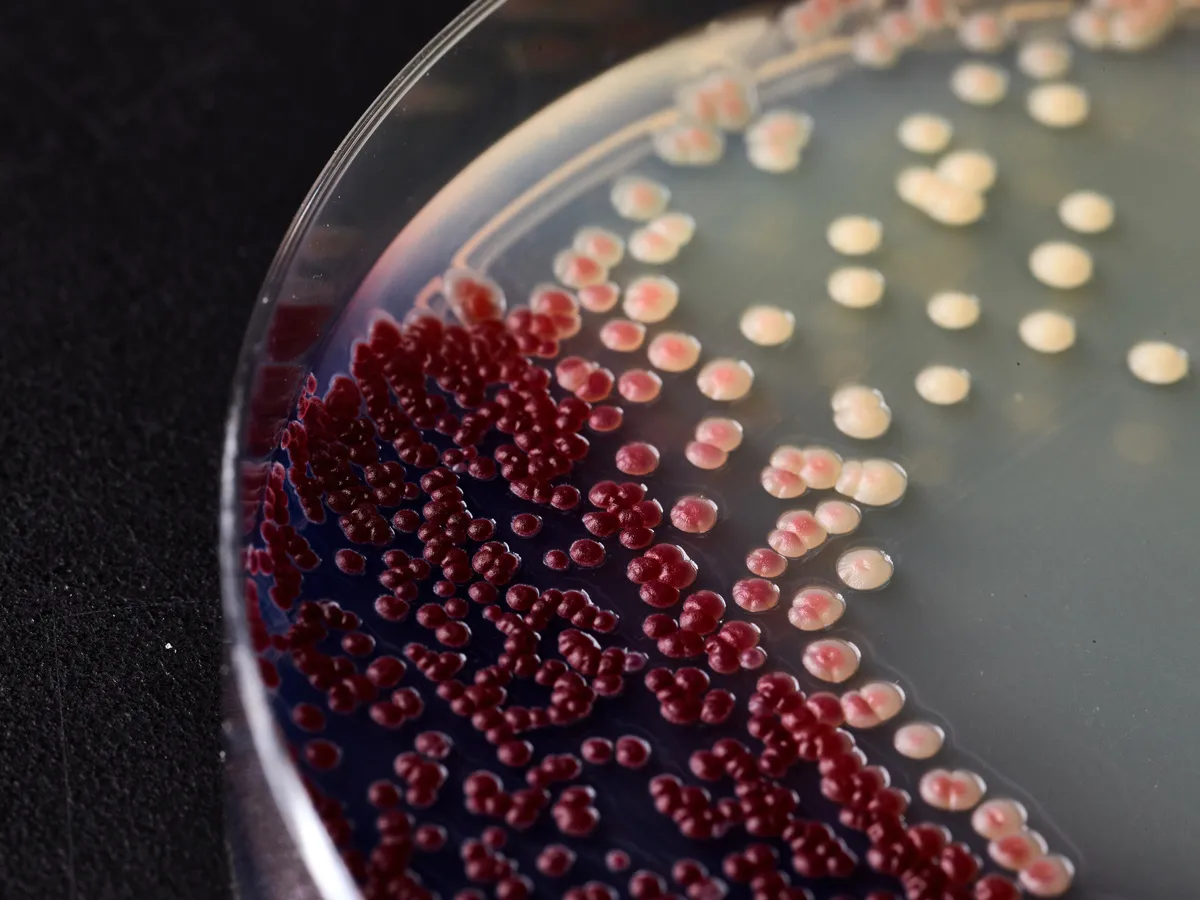

Ginkgo.Your Innovation Partner.
Earlier today, the US Senate passed the final version of the FY 2022 National Defense Authorization Act (NDAA), which establishes a National Security Commission on Emerging Biotechnology. From here, the Act heads to the White House for President Biden’s signature. Its passage signifies the increasing importance of biotechnology and synthetic biology to competitiveness and national security.
The Commission comes at a critical time for national and international biosecurity. As communities around the globe continue the fight against COVID-19, we are relying on synthetic biology to give us the tools to test, vaccinate, and protect global populations. Further, synthetic biology and biotechnology are vital tools in our efforts to address climate change and meet emissions reductions targets. It’s essential that governments do all they can to support the growth of these critical technologies.
Once established, the new Commission will consider the methods and means necessary to advance the development of synthetic biology, bioengineering, and associated technologies to comprehensively address the national security and defense needs of the United States while enabling a thriving bioeconomy. Specifically, the Commission will present a strategy to establish the United States as the leader in the global bioeconomy. This will include clearly outlined steps the country must take to responsibly use synthetic biology for national security and defense – including the defense against biological threats – and promote synthetic biology innovation.
The time is ripe for such an effort, and we applaud it.
According to McKinsey & Co., in the next 10-20 years, industrial applications of biology are expected to generate direct economic impacts of up to $4 trillion per year, much of which is expected to result from applications of biotechnology such as those created by cell developers on our platform.
At Ginkgo, we’ve long believed that synthetic biology is the next frontier of biotechnology and biosecurity. Countries around the world are heavily investing in this technology, and the National Security Commission on Emerging Biotechnology will help the United States better understand the needs of the domestic and global bioeconomy and the biosecurity landscape presented by the first decades of this biological century.
We applaud Armed Services Chairman Sen. Jack Reed (D-RI) and Rep. Adam Smith (D-WA-9), and Ranking Members Sen. James Inhofe (R-OK) and Rep. Mike Rogers (R-AL-3), as well as Reps. Mike Gallagher (R-WI-8) and Seth Moulton (D-MA-6) for their bipartisan leadership in establishing this important Commission.
Posted by Jason Kelly